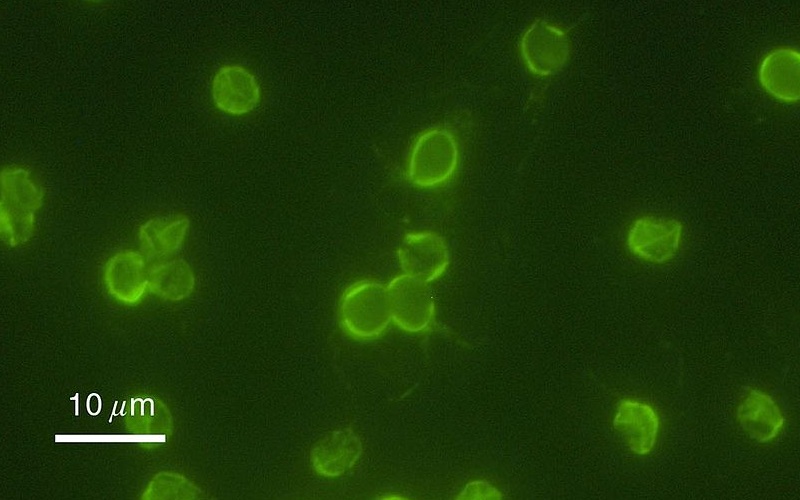
cryptosporidium

La infecciones gastrointestinales causadas por Cryptosporidium spp. se asocian frecuentemente al uso de aguas recreativas o al agua de consumo. El Ministerio de Sanidad ha publicado "Recomendaciones ante la presencia de Cryptosporidium en agua", un extenso documento sobre la presencia y prevención de este parásito en el agua, asi como su detección y recuento en aguas de consumo y piscinas.
Cryptosporidium spp. en agua de consumo y piscinas
Cryptosporidium spp. es un protozoo parásito de transmisión fecal-oral que se transmite principalmente por el agua. En la UE los casos de criptosporidiosis se asocian principalmente a la ingestión de ooquistes de Cryptosporidium spp. durante el baño en piscinas, o al consumo de agua de red contaminada.
Los casos de criptosporidiosis, que causa fiebre, dolores intestinales y diarrea, son de declaración obligatoria en España desde 2015, sin embargo se considera una enfermedad infranotificada.
En 2023 se detectó un extraordinario incremento de casos y brotes de criptosporidiosis en la gran mayoría de comunidades autónomas (CCAA), que afectó especialmente a niños/as menores de 4 años. Ante esa situación, el Ministerio de Sanidad emitió una Evaluación Rápida del Riesgo, entre cuyas conclusiones se encuentran la necesidad de intensificar la vigilancia de Cryptosporidium spp. en España y de establecer protocolos de vigilancia ambiental del parásito.
Vigilancia de Cryptosporidium spp. en el agua
Recordemos que en España Cryptosporidium spp. no se vigila de manera sistemática en el agua, a no ser en el contexto de la investigación ambiental de un brote.
En el Real Decreto 742/2013, por el que se establecen los criterios técnico-sanitarios de las piscinas, no se establece explícitamente el control de Cryptosporidium spp., pero se señala que el agua de la piscina deberá estar libre de organismos patógenos que puedan suponer un riesgo para la salud humana. Sin embargo, la determinación de la presencia de este parásito en el agua sólo se realiza en caso de brote.
En el caso del agua de consumo, en el Real Decreto 3/2023, por el que se establecen los criterios técnico-sanitarios de la calidad del agua de consumo, se establece que el agua de consumo debe estar libre de microorganismos o parásitos que puedan suponer un riesgo para la salud humana. Aun así, Cryptosporidium spp. no es un microorganismo de control rutinario en agua de consumo, debido a la dificultad del muestreo y analisis. No obstante, en determinadas situaciones si que se monitoriza Clostridium perfringens como posible indicador de Cryptosporidium spp.
En este contexto, el Ministerio de Sanidad ha publicado recientemente un extenso documento sobre Cryptosporidium spp. en el agua de abastecimientos con y sin ETAP, y en piscinas e instalaciones de uso recreativo. El documento incluye, además, un procedimiento que permite la identificación morfológica y enumeración de ooquistes de Cryptosporidium en el agua, a nivel de género.

Ooquistes de Cryptosporidium / CDC
Recomendaciones para prevención y control de Cryptosporidium spp.
Tres de los capítulos del documento de Sanidad están dedicados a la presencia de Cryptosporidium en:
- abastecimientos con ETAP
-
abastecimientos sin ETAP
-
piscinas e instalaciones de uso recreativo
En ellos se incluyen recomendaciones para la implementación de medidas preventivas frente al parásito en las diferentes fases de tratamiento del agua, así como medidas correctoras ante diferentes escenarios posibles.
Procedimientos para la detección y recuento de ooquistes de Cryptosporidium
El capítulo 6 presenta un procedimiento para la detección y recuento de ooquistes de Cryptosporidium en aguas de consumo humano y piscinas, realizado en base a la revisión de tres protocolos estandarizados:
-
Method 1623.1 Cryptosporidium and Giardia in Water by Filtration/IMS/FA de la Environtmental Protection Agency (EEUU)
-
ISO 15553:2006Water quality — Isolation and identification of Cryptosporidium oocysts and Giardia cysts from water
-
The Microbiology of Drinking Water (2010) - Part 14 - Methods for the isolation, identification and enumeration of Cryptosporidium oocysts and Giardia cysts.
El procedimiento descrito permite la identificación morfológica y la enumeración de ooquistes de Cryptosporidium sólo a nivel de género, no de especie y genotipo, para lo que se requeriría la aplicación de técnicas moleculares complementarias. Tampoco permite determinar la viabilidad o infectividad de los ooquistes detectados.
Este procedimiento consta de 3 fases:
- Concentración: El aislamiento de ooquistes de Cryptosporidium a partir de matrices acuáticas requiere el uso de un método que permita concentrar en un pequeño volumen los microorganismos presentes en la muestra. La técnica descrita es la de filtración a través de un cartucho/cápsula con un tamaño de poro nominal de 1 µm que retiene los ooquistes de Cryptosporidium (cuyo tamaño es de 4–6 µm), seguido de una elución y una centrifugación a baja velocidad.
- Purificación: Después de la concentración mediante filtración se procede a la purificación de los ooquistes de Cryptosporidium mediante separación inmunomagnética. Esta tecnología se basa en el uso de partículas paramagnéticas recubiertas con anticuerpos monoclonales específicos contra proteínas de la pared del ooquiste. Las partículas se retiran del material no deseado mediante lavados sucesivos utilizando una gradilla magnética. Finalmente, los ooquistes son disociados de las partículas paramagnéticas usando una solución ácida que deberá neutralizarse.
- Detección y enumeración: A partir de la suspensión de ooquistes purificados obtenidos en el paso anterior se realiza una inmunofluorescencia directa utilizando anticuerpos monoclonales marcados con fluoresceína (FITC). Adicionalmente, para ayudar en la identificación, se realiza una tinción con una solución de diamidino-phenylindol (DAPI), un agente intercalante del ADN que tiñe de azul los núcleos de los ooquistes del parásito. Cada muestra se examina en un microscopio de epifluorescencia para confirmar la presencia y número de ooquistes de Cryptosporidium.
Ooquistes de Cryptosporidium. Imagen de microscopía de inmunofluorescencia / EPA/H.D.A. Lindquist
Métodos alternativos
El principal inconveniente de los métodos estandarizados para la detección y recuento de ooquistes de Cryptosporidium en matrices acuáticas es el elevado coste operativo de los elementos usados en los procesos de concentración (filtros, cápsulas) llevados a cabo en los muestreos de campo y de purificación (IMS) y enumeración (inmunofluorescencia directa) realizados en el laboratorio.
Por este motivo, diferentes estudios han tratado de adaptar/implementar tecnologías ya existentes para mejorar este procedimiento de forma más coste-efectiva. En el documento del Ministerio de Sanidad se resumen los principales métodos alternativos propuestos para este fin y se discuten sus ventajas y desventajas:
- Centrifugación de flujo continuo
- Ultrafiltración
- Filtración en membrana de celulosa
- Reacción en cadena de la polimerasa (PCR)
Simulación de una evaluación del riesgo de infección
Por último, se incluye un ejercicio de simulación de evaluación del riesgo cuantitativo para Cryptosporidium en el agua, que permite estimar el riesgo de infección.
Se trata de un simulacro para valorar las posibilidades de utilización de los modelos de evaluación cuantitativa del riesgo microbiológico (QMRA) y las calculadoras diseñadas con este fin, y, en particular, la recogida en la “Guía práctica para la elaboración de un Plan Sanitario del agua en una zona de abastecimiento. Tomo II. Evaluación cuantitativa”, elaborada por el Ministerio de Sanidad.
Las variables principales calculadas son: la dosis de exposición de la población o dosis estimada diaria y el riesgo de infección/año.
Referencia:
Recomendaciones ante la presencia de Cryptosporidium en agua, Ministerio de Sanidad, 2025





